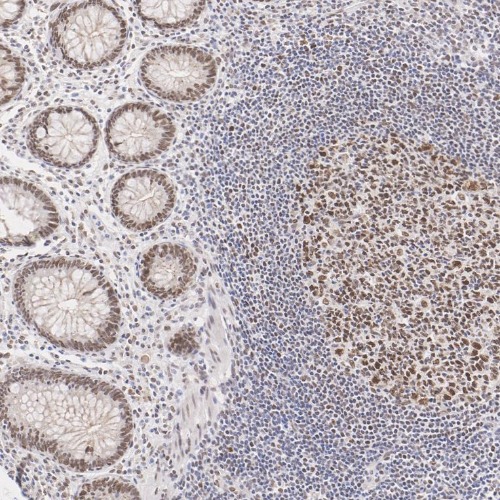

MLH1 Mouse Monoclonal Antibody(ARA721)
CAT.NO. : ARA6501
RMB Please choose
RMB Please choose
*产品价格可能会有所调整,请以品牌方官网实时更新的价格为准,以确保准确性。
Background
MutL Homolog 1 (MLH1) is a protein involved in the mismatch-repair pathway. This protein is commonly associated with hereditary non-polyposis colorectal cancer, as the MLH1 gene is frequently mutated in patients with this cancer. Studies have shown MLH1 to be deficient in a high percentage of patients with microsatellite instability, as well as endometrial and ovarian cancers. Use of Anti-MLH1 is optimized when paired in an IHC panel with MSH6, MSH2, and PMS2. Anti-MLH1 is useful in the detection of MLH1 in a number of normal and neoplastic tissues, and for identifying a loss of MLH1 in tumours that are microsatellite-unstable.
Application
|
Application |
Dilution Ratio |
|
WB |
1:200-1:2000 |
|
IHC-P |
1:200-1:1000 |
Overview
|
Antibody Type |
Recombinant Mouse Monoclonal Antibody |
|
Species Reactivity |
Human |
|
Validated Applications |
WB, IHC |
|
Molecular Weight |
Predicted band size: 85 kDa |
|
Positive Control |
SW480 cell lysate, HeLa cell lysate, human appendix tissue, human colon carcinoma tissue, SW480. |
|
Conjugation |
unconjugated |
|
Form |
Liquid |
|
Storage Buffer |
PBS (pH7.4), 0.1% BSA, 40% Glycerol. Preservative: 0.05% Sodium Azide. |
|
Isotype |
IgG1 |
|
Purification Method |
Protein A affinity purified. |
Data
Immunohistochemical analysis of paraffin-embedded human appendix tissue with MLH1 Mouse Monoclonal Antibody(ARA721).
Storage
Store at 4°C short term. For long term storage, store at -20°C, avoiding freeze/thaw cycles.
Research Use Only
For Research Use Only. Not for use in diagnostic procedures.
New Products
